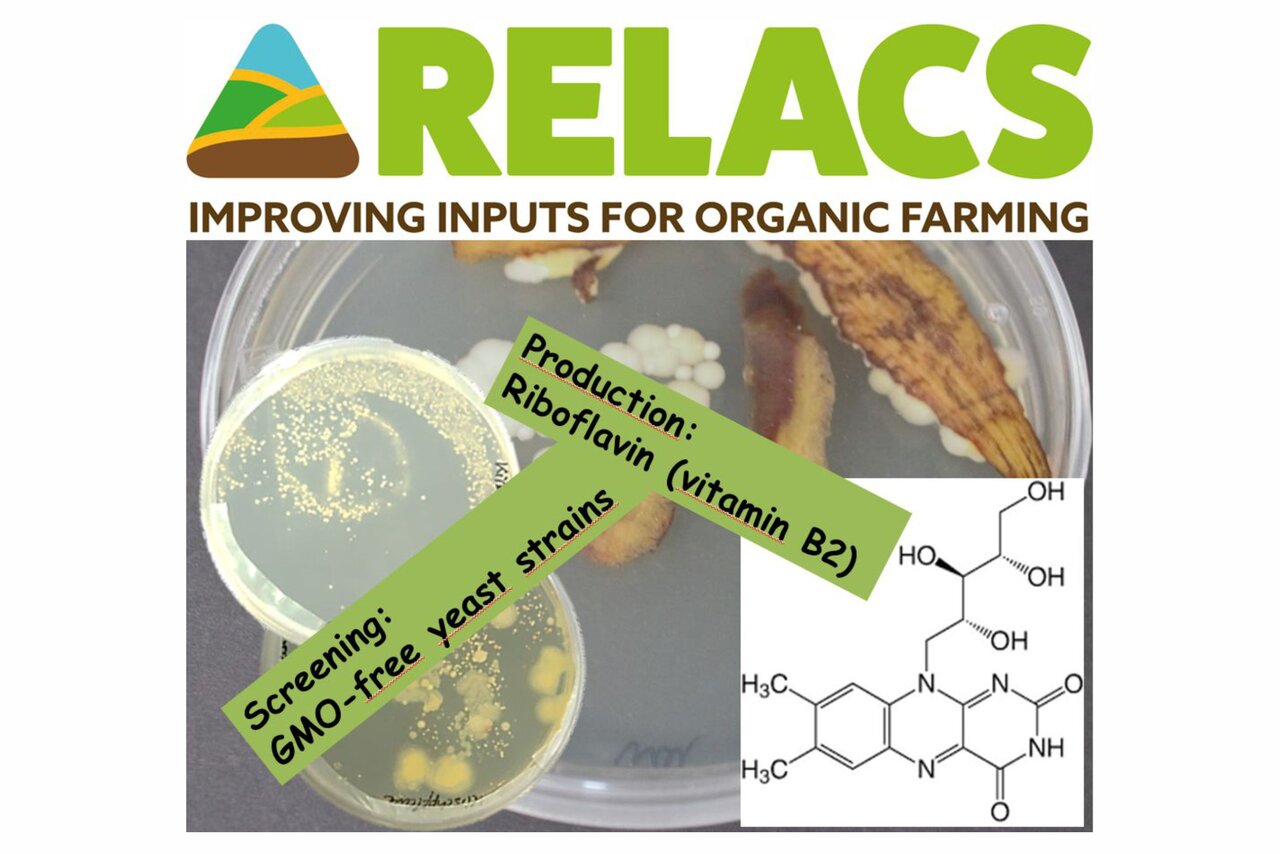

Institut für
AT Agrartechnologie
Projekt
Betriebsmittel im biologischen Landbau verbessern
Betriebsmittel im biologischen Landbau verbessern
RELACS ermöglicht Landwirtschaftsorganisationen, Beratungsdiensten und Forschern, gemeinsam zu noch höheren Umweltstandards im biologischen Landbau beizutragen.
Hintergrund und Zielsetzung
Biobauern halten sich an hohe Standards bei der Herstellung von qualitativ hochwertigen Lebensmitteln und schonen gleichzeitig die Umwelt. Der Biolandbau muss jedoch kontinuierlich verbessert werden, um seine ehrgeizigen Ziele zu erreichen. RELACS wird die Entwicklung und Einführung kosteneffizienter und umweltfreundlicher Tools und Technologien fördern, um:
- den Einsatz von Kupfer und Mineralöl im Pflanzenschutz zu reduzieren,
- nachhaltige Nährstoffquellen für die Pflanzenernährung zu identifizieren und
- Lösungen zur Unterstützung der Tiergesundheit und des Tierwohls bereitzustellen.
Als Systemansatz für eine nachhaltige Landwirtschaft zielt der Biolandbau darauf ab, ökologische Prozesse effektiv zu nutzen und gleichzeitig die Abhängigkeit von außerbetrieblichen Betriebsmitteln zu verringern. Die RELACS-Partner werden Lösungen evaluieren, um den Einsatz von Betriebsmitteln in ganz Europa sowie in den Ländern am südlichen Mittelmeer weiter zu reduzieren. Weiter werden sie wissenschaftliche Unterstützung leisten, um faire und umsetzbare EU-Vorschriften zur Verbesserung der derzeitigen Praktiken im biologischen Landbau zu entwickeln. Zudem werden sich landwirtschaftliche Beratungsnetze in elf europäischen Ländern an die Landwirte wenden, um eine wirksame Verbreitung und Anwendung der Tools und Techniken zu gewährleisten.
RELACS baut auf den Ergebnissen früherer Forschungsprojekte auf und entwickelt fortgeschrittene Lösungen weiter.
In dem EU-Verbundprojekt ist es die Aufgabe des Thünen-Instituts, neue Riboflavin (Vitamin B2) produzierende Wildtyp-Mikroorganismen (ohne GMO) zu identifizieren und diese GMO-freien Stämme zu optimieren.
Riboflavin kann von Pflanzen und Mikroorganismen synthetisiert werden, aber höhere Eukaryoten (z. B. Tiere) können Riboflavin nicht selber herstellen. Daher muss Riboflavin der Nahrung zugesetzt werden. Industriell wird Riboflavin zurzeit mit genetisch veränderten Mikroorganismen hergestellt.
Vorgehensweise
Es werden zwei verschiedene Ansätze verfolgt, um neue Riboflavin-Überproduzenten zu finden, um eine kontinuierliche Versorgung mit Riboflavin bei der ökologischen Tierhaltung sicherzustellen. Zum einen werden neue Riboflavin-Produzenten aus speziellen Lebensräumen isoliert. Zum anderen werden anhand des phylogenetischen Stammbaums bekannter, natürlich überproduzierender Riboflavin-Stämme neue, bisher unbekannte Riboflavin-Produzenten identifiziert.
Nach der Isolierung werden die neuen potenten Riboflavin produzierenden Stämme mittels Bioverfahrenstechnik optimiert. Der Fermentationsprozess wird im Labormaßstab optimiert, um eine hohe Raum-Zeit-Ausbeute und die beste volumetrische Produktivität von Riboflavin zu erreichen.
Ergebnisse
DOI:10.3220/PB1687161924000
Links und Downloads
Thünen-Ansprechperson

Thünen-Beteiligte
Beteiligte externe Thünen-Partner
-
The International Federation of Organic Agriculture Movements EU (IFOAM EU)
(Brüssel, Belgien) -
Fondazione Edmund Mach di San Michele all’Adige
(S. Michele all’Adige (TN), Italien) - Julius Kühn-Institut - Bundesforschungsinstitut für Kulturpflanzen (JKI)
(Quedlinburg, Braunschweig, Groß Lüsewitz, Kleinmachnow, Deutschland) -
Scotland's Rural College (SRUC)
(Edinburgh, Großbritannien (inkl. Nordirland)) - University of Copenhagen
(Kopenhagen, Helsingoer, Dänemark) -
Universität Hohenheim
(Hohenheim, Deutschland) -
Mediterranean Agronomic Institute of Bari (CIHEAM IAMB)
(Valenzano, Italien) - ITAB - L’Institut Technique de l’Agriculture Biologique
(Paris, Frankreich) -
Norsk institutt for bioøkonomi (NIBIO)
(Ås, Norwegen) -
ÖMKi Hungarian Research Institute of Organic Agriculture
(Budapest, Ungarn) -
Trifolio-M
(Lahnau, Deutschland) -
SubstainTec GmbH
(Frick, Schweiz) -
Biological Products for Agriculture (bi-pa)
(Londerzeel, Belgien) -
University of Trento
(Trento, Italien) -
Økologisk Landsforening
(Åbyhøj, Dänemark) -
Bioforum Vlaanderen
(Antwerpen, Belgien) -
Bioselena
(Karlovo, Bulgarien) - Naturland - Verband für ökologischen Landbau e.V.
(Gräfelfing, Deutschland) -
Ecovalia
(Sevilla, Spanien) -
Soil Association
(Bristol, Großbritannien (inkl. Nordirland)) -
FederBio
(Bologna, Italien) -
Öko-Obstbau Norddeutschland (OeON)
(Engelschoff-Neuland, Deutschland) -
Estonian Organic Farming Foundation (EOFF)
(Tallinn, Estland) -
The French research institute for perfume, medicinal and aromatic plants (ITEIPMAI)
(Chemillé-Melay, Frankreich) -
Fédération des Eleveurs et Vétérinaires En Convention (FEVEC)
(St Symphorien Sur Coise, Frankreich) - Institut d’Élevage (IDELE)
(Paris, Limoges, Mignaloux-Beauvoir, Frankreich) -
Adage 35
(Cesson-Sevigne, Frankreich) - Forschungsinstitut für biologischen Landbau (FiBL)
(Frick, Schweiz)
Zeitraum
5.2018 - 4.2022
Weitere Projektdaten
Projektfördernummer: Grant Agreement 773431
Förderprogramm: EU – Horizon 2020 – Societal Challenge "Food Security, Sustainable Agriculture and Forestry, Marine, Maritime and Inland Water Research and the Bioeconomy"
Projektstatus:
abgeschlossen
Publikationen zum Projekt
- 0
Kuenz A, Bromann S (2023) Betriebsmittel im biologischen Landbau verbessern (RELACS). Braunschweig: Thünen-Institut für Agrartechnologie, 2 p, Project Brief Thünen Inst 2023/30, DOI:10.3220/PB1687161924000
- 1
Kuenz A, Tölle M, Bromann S (2023) Investigations on riboflavin production by wild-type yeast strain for supplementation of organic feed. Organic Agric 13(3):399-410, DOI:10.1007/s13165-023-00435-4
- 2
Kuenz A, Bromann S (2023) Replacement of Contentious Inputs in Organic Farming Systems (RELACS). Braunschweig: Thünen Institute of Agricultural Technology, 2 p, Project Brief Thünen Inst 2023/30a, DOI:10.3220/PB1687162447000
- 3
Kuenz A, Leiber F (2022) New vitamin B2 producing wild-type yeast strain (GMO-free) [online]. Frick; Brussels; Braunschweig: FiBL; IFOAM Organics Europe; Thünen Institute of Agricultural Technology, 2 p, zu finden in <https://relacs-project.eu/resources/practical-guidelines/> [zitiert am 21.06.2023]




